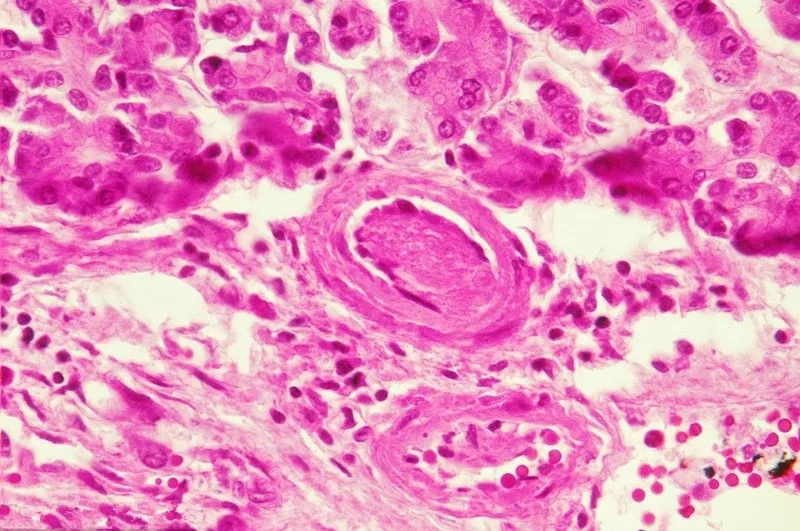
儿童常见特发性血小板减少性紫癜（ITP）的发病原因

特发性血小板减少性紫癜(ITP)是一种由于患者体内产生自身抗血小板抗体,致使血小板寿命缩短、破坏过多、数量减少为病理特征的自身免疫性疾病。ITP也是儿童时期最常见的出血性血液病之一。且发病初期多是急性期,病程较短,积极治疗后,患儿可恢复正常。但也有极少患儿病情多年不愈,或者是并发严重内出血威胁生命。
血小板减少并非恶性病,但是也会让家长们担惊受怕。且近年来,儿童发病率逐年上升,为何血小板减少儿童发病率这么高呢?下面我们具体看一下。
儿童这个年龄段身体各项机能尚不完善,容易受到外界各种因素的影响,尤其是疾病感染等,而儿童患者常见的感染以及ITP的相关诱发因素如下:
1.病毒感染
部分ITP患儿发病前1~2周左右,有病毒感染史,如上呼吸道感染,风疹,麻疹,腮腺炎,水痘,带状疱疹,EB病毒等等。
2.肺炎支原体感染
研究表明ITP患儿 MP抗体IgM阳性与正常儿童比较差异有显著性,提示MP感染可能与ITP的发生有关。
3. 细菌感染
链球菌感染所致的急性肾小球肾炎患者体内可见血小板相关抗体PA IgM升高可引发ITP疾病的发生;此外,有资料显示,幽门螺旋杆菌感染是引发儿童ITP的原因之一。
4. 药物相关性ITP
药物介导的或药物依赖性ITP,而目前认为下列药物与ITP的发生有关:利巴韦林、顺铂、肝素、奎宁、卡马西平、萘普生等。
5. 疫苗导致的相关ITP
极少的ITP患儿血小板减少病情发生在疫苗接种2-8周,类似于病毒或细菌感染。由此可见,之所以儿童血小板减少性紫癜发病率较高,与其自身特殊的体质阶段是有关系的。作为家长,关键是帮助孩子做好血小板减少的防治,最容易的就是日常生活中预防感冒、感染的发生。

如果家长发现孩子有出血点、或者自发出血一定要及时到医院进行处理,一旦确诊,最好尽快系统治疗,切勿耽误最佳治病良机。早发现、早治疗、早康复。